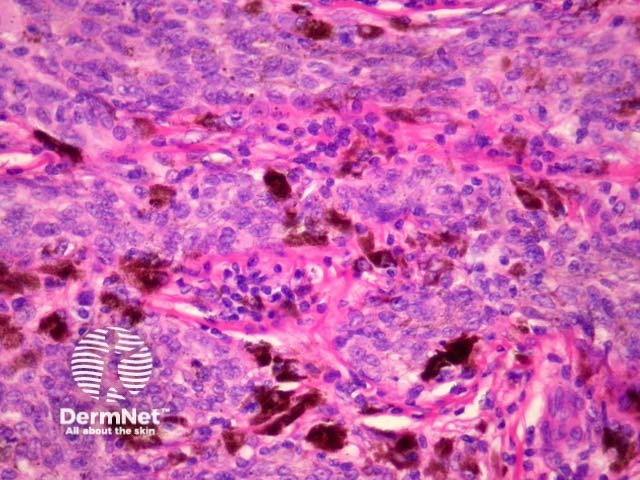
Figure 17
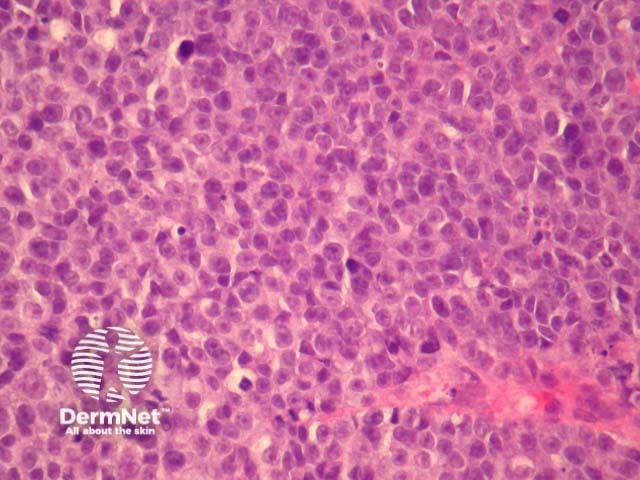
Figure 27
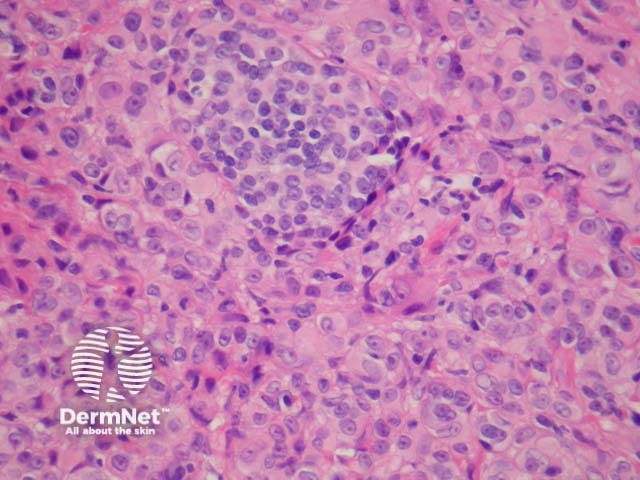
Figure 30

Main menu
Common skin conditions
NEWS
Join DermNet PRO
Read more
Quick links
Lesions (cancerous) Diagnosis and testing
Author: A/Prof Patrick Emanuel, Dermatopathologist, Auckland, New Zealand; Harriet Cheng BHB, MBChB, Dermatology Department, Waikato Hospital, Hamilton, New Zealand, 2013.
Histology
Superficial spreading melanoma
Nodular melanoma
Lentigo maligna melanoma
Lentiginous melanoma
Acral lentiginous melanoma
Desmoplastic melanoma
Other histological variants of melanoma
Metastatic melanoma
Differential diagnosis
Sentinel lymph node pathology
Diagnostically ambiguous melanocytic neoplasm (DAMN)
Melanoma is the fourth most common cancer in New Zealand and incidence is increasing. New Zealand has the highest rate of melanoma worldwide and risk is greatest for non-Māori men aged over 50 years. The clinical lesion is usually an irregularly shaped, asymmetrical lesion with varying colors with a history of recent change in size, shape, colour or sensation. Melanoma may arise de novo or within an existing benign or dysplastic naevus.
Most melanomas have an initial radial growth phase within the epidermis and sometimes within the papillary dermis (figure 1, 2), which may be followed by a vertical growth phase with deeper extension (figures 3, 4). The exception to this is nodular melanomas, which either skip the radial growth phase or the radial phase is rapidly overrun by the vertically growing tumour. It is also possible that they arise within dermal melanocytes. It has been proposed that lesions in the radial growth phase are incapable of metastasis, however there are numerous examples of thin melanomas that have behaved aggressively, even without convincing evidence of vertical growth.

Figure 1

Figure 2

Figure 3

Figure 4
Histologically, melanomas are asymmetrical and poorly circumscribed lesions with architectural disturbance and usually marked cytological atypia. Specific features include consumption of the epidermis, pagetoid spread of melanocytes, nests of melanocytes with variable size and shape (which may be confluent and lack maturation), melanocytes within lymphovascular spaces, deep and atypical mitoses and increased apoptosis. Ulceration, if present, is a poor prognostic factor. Mitotic figures are common.
Melanoma cells can be categorized in two major types: epithelioid and spindle cells. Epithelioid cells are large and round with abundant eosinophilic cytoplasm, prominent vesicular nuclei and large nucleoli. They most commonly arise in superficial spreading and nodular melanomas.
Pathology reports of melanoma will include a description of tumour thickness, which can be expressed as Clark level or Breslow thickness. Clark level is a decrete measure indicative of the anatomical level of invasion. Assessment of the Clark level was considered too subjective for cancer staging so has been removed from the latest edition of the AJCC cancer staging manual. Many pathologists still report the Clark level to avoid unnecessary telephone conversations.
Clark level |
Level of invasion |
|
|---|---|---|
1 |
Epidermis (in-situ melanoma) |
|
2 |
Papillary dermis |
|
3 |
Papillary/reticular dermal interface |
|
4 |
Reticular dermis |
|
5 |
Subcutis |
|
Breslow thickness is expressed in millimeters and measures depth from the granular layer of the epidermis to the deepest part of the tumour (figure 5). Breslow thickness is strongly correlated with melanoma survival and is a component of the clinical staging system for melanoma.
Indicators of poor prognosis in melanoma are listed in the table below.
Clinical indicators |
Histological indicators |
|---|---|
Increased age |
Increased Breslow thickness |
Site: back, upper arm, neck, scalp |
Vertical growth phase |
Males |
Ulceration (figure 6) |
Maori and Pacific Islanders |
|
The term ‘in situ’ refers to a tumour which has not breeched the basement membrane. Thus melanoma in situ is melanoma confined to the epidermis without dermal invasion. Melanoma in situ may be cured with simple excision and require a narrower excision margin than invasive melanoma (unless margins are unclear as is often the case with facial melanoma in situ).
It should be noted that within the same lesion areas invasive tumour are often surrounded by an in-situ component making clinicopathological correlation vital. Serial sectioning and immunohistochemical studies should be performed to exclude superficial cases in some cases. Figure 9 shows the Melan-A stain for a case of what was thought to be a melanoma in situ on routine sections. Melan-A revealed rare positive cells in the dermis indicative of early invasion.

Figure 5

Figure 6

Figure 7

Figure 8

Figure 9
Superficial spreading melanoma (SSM) is the most common melanoma variant. These tumours are most commonly found on the back in males and legs in females. Histologically they are characterised by atypical epithelioid melanocytes, found singly or in clusters, scattered throughout the epidermis (known as ‘buckshot scatter’). Tumour cells have abundant cytoplasm, nuclear pleomorphism and prominent nucleoli. Melanocyte proliferation can be seen extending over the tips of the papillae in continuity from one rete ridge to another. Adnexae may be involved. Thinning or consumption of the epidermis may occur. Invasive dermal components show lack of maturation and varying degrees of atypia. See Figures 10, 11, 12, 13, 14, 15.

Figure 10

Figure 11

Figure 12

Figure 13

Figure 14

Figure 15
Nodular melanoma (NM) presents as a rapidly enlarging nodule. Histologically there is a dermal mass of dysplastic tumour cells with upward epidermal invasion but minimal adjacent epidermal spread or horizontal growth. Tumour cells are often round and epithelioid in morphology with hyperchromatic nuclei. See Figure 16, 17.

Figure 16
Figure 17
Lentigo maligna melanoma (LMM) is a subtype of melanoma, which occurs on chronic sun exposed skin of scalp, face or neck. Frequency increases with age. Lentigo maligna is the precursor lesion and is a form of melanoma in-situ. The clinical lesion is an irregularly shaped and pigmented macule, which slowly enlarges (figure 18). Melan-A can be helpful to delineate the lesion and illustrate follicular invasion (figure 19).
Epidermal changes in lentigo maligna melanoma include variable epidermal atrophy and proliferation of dysplastic melanocytes at the dermoepidermal junction with extension to adnexal structures. Epidermal pigmentation is variable but may involve the entire epidermis. In more advanced lesions (figure 20) focal junctional nests may be present and multinucleate melanocytes with prominent dendritic processes are commonly seen. Pagetoid spread may be absent.
Dermal changes include solar elastosis and the presence of melanophages and small foci of lymphocytes. Invasive foci may be missed on haematoxylin and eosin staining but detected with special stains (figure 9, above).

Figure 18

Figure 19

Figure 20
Lentiginous melanoma is a newly classified form of melanoma, and is a slowly progressing variant occurring on sun-damaged skin of the trunk and limbs. Histological features include lentiginous hyperplasia as well as focal junctional nests of melanocytes with varying cytological atypia and pagetoid spread of single melanocytes (figures 21, 22).

Figure 21

Figure 22
Acral lentiginous melanoma (ALM) is the most common variant of melanoma in people with dark skin but arises at equal frequency in all races. Acral lentiginous melanomas are found on the digits (including under nails), on the palms, and the plantar aspects of the feet. Subungual melanomas may also be superficial spreading or nodular variants.
Acral lentiginous melanoma may have spindled or epithelioid cellular morphology. Changes may be subtle with scattered atypical melanocytes located close to the basal layer. Epidermal acanthosis, elongation of rete ridges and extension along sweat ducts are typical features (figure 23).
Immunohistochemistry of subungual melanoma is S100 negative but HMB45 positive.

Figure 23
Desmoplastic melanoma (DM) is characterised by tumour cells which produce a fibromucinous matrix. Over half of cases occur on the head and neck. Clinically these are slow growing often non-pigmented lesions, which may resemble scar tissue. Some cases probably start their evolution as lentigo maligna melanoma.
On histology there are spindle-shaped tumour cells within the dermis and subcutis surrounded by mature collagen bundles. The relative proportion of tumour cells to surrounding stroma is variable. When there are an abundance of tumour cells the lesion may be reported as spindle-cell melanoma. These tumours are usually deeply infiltrative and accurate identification of depth of invasion often relies on the use of special stains. Scattered lymphoctyes and plasma cells within the tumour may be a clue to diagnosis. Less cellular variants may be mistaken for dermatofibroma. See Figures 24, 25.
These tumours are often negative with immunohistochemical studies for HMB-45 and Melan-A but S100 or SOX10 can be very helpful because these are practically always positive (see figure 26).
Neurotropic melanoma describes a variant of desmoplastic melanoma where there is infiltration of nerves and tumour cells can be seen arranged in a concentric fashion around nerve fibres. This variant has a high rate of local recurrence.

Figure 24

Figure 25

Figure 26
Primary dermal melanoma |
Melanoma deposit in dermis or subcutis with no in-situ component possibly due to regression or derivation from non-epidermal melanocytes. |
|
Minimal deviation melanoma |
Minimal histological deviation from benign naevi. Melanoma cells display only mild atypia. This is a diagnosis by subpoena (pathologist becomes aware the lesion was a melanoma when required in court to face litigation) |
|
Naevoid melanoma |
Vertical growth phase melanoma easily confused with a benign naevus. |
|
Small cell melanoma |
Melanoma cells are small with minimal cytoplasm, round hyperchromatic nuclei and prominent nucleoli (figure 27). |
|
Signet ring melanoma |
Signet ring cells have large pale cytoplasmic globular inclusions, which compress the nucleus (figure 28). |
|
Rhabdoid melanoma |
Presence of large epithelioid cells with abundant cytoplasm containing a round eosinophilic inclusion (figure 29). |
|
Balloon and clear cell melanoma |
Tumour cells have abundant eosinophilic or clear cytoplasm with fine granular or vacuolar change. |
|
Myxoid melanoma |
Feature of vertical growth phase melanoma. Tumour cells my be small with mucin deposition appearing as basic material which is PAS negative and Alcian blue positive. |
|
Melanoma with neuroendocrine differentiation |
Immunohistochemical expression of chromogranin and synaptophysin. |
|
Malignant blue naevus |
Predilection for scalp. Melanoma may arise in common or cellular blue naevi as well as naevi of Ota and Ito. |
|
Pseudovascular melanoma |
Angiotropism with melanoma cells around and infiltrating vessel walls or angiomatoid change with blood-filled endothelium-lined spaces reminiscent of angiosarcoma. |
|
Metaplastic melanoma |
Metaplastic elements such as bone, cartilage and smooth muscle may be found within melanoma, particularly acral lentiginous lesions. |
|
Epidermotropic metastatic melanoma |
Metastatic melanoma with epidermal involvement may be difficult to distinguish from a synchronous lesion. Features suggesting metastasis are extensive lymphovascular invasion. |
|
Blue naevus-like metastatic melanoma |
Metastatic deposits may have clinical and histological features of a blue naevus with subtle cytological atypia. |
|
Dermal squamomelanocytic tumour |
Consists of two distinct populations of tumour cells: squamous cells and melanocytes. |
|
Basomelanocytic tumour |
Combination (collision) of basal cell carcinoma with melanoma. |
|
BAP-1 mutation associated melanoma |
These melanomas arise as a result of a mutation in the BAP-1 gene and usually have a Spitzoid morphology (figure 30). Figure 31 confirms negative staining with BAP-1. |
|
Figure 27

Figure 28

Figure 29
Figure 30

Figure 31
Cutaneous metastasis of melanoma can cause diagnostic confusion. The metastatic melanoma may invade the dermis or subcutis and form a nodular tumour mass without invasion of the overlying epidermis (figure 1). The pattern of growth may mimic a benign intradermal naevus at low power (figure 1) but at high power examination the nuclear atypia is usually obvious, there may be mitoses and there is minimal evidence of maturation (decrease in cell size) with descent in the dermis (figure 2). Usually the lack of epidermal involvement is a good clue the tumour is a metastasis from another site but sometimes the metastasis may invade the epidermis and closely simulate a primary melanoma.
Rarely, melanoma which has metastasised to the dermis may closely mimic a blue naevus (blue naevus-like melanoma, figures 3,4). This can cause considerable diagnostic difficulty and be impossible to correctly recognise without clinical information.

Figure 1

Figure 2

Figure 3

Figure 4
When pigmentation is absent, spindle morphology melanoma may be difficult to distinguish from other spindled cell tumours including leiomyosarcoma, spindled cell squamous cell carcinoma, atypical fibroxanthoma and dermatofibrosarcoma protuberans. In these cases special stains are helpful in distinguishing melanocyte origin of tumour cells.
Amelanotic epithelioid tumours may be confused with anaplastic carcinoma, Langerhan cell histiocytosis and anaplastic lymphoma.
Benign nodal naevi are not rare. One of the problems we have as pathologists with the advent of sentinel lymph node biopsies is how to interpret collections of melanocytes in the lymph node – are they bland naevus cells or small deposits of metastatic melanoma? The problem is amplified when the initial lesion was diagnostically ambiguous. In our opinion sentinel lymph nodes should not be performed to help determine whether an unusual primary lesion in the skin is a melanoma or an unusual naevus. Extensive parenchymal rather than capsular involvement, nuclear atypia, immunohistochemical positivity for HMB-45 are some helpful features in diagnosing metastatic melanoma in a sentinel lymph node.
There are strict protocols for examining sentinel lymph nodes for patients with known melanoma. This involves examination of numerous levels and immunohistochemical stains. Given the resources and time involved it’s prudent for clinicians to accept a slightly longer time for reporting these cases. Frozen sections have no place in clinically and radiologically non-suspicious sentinel lymph nodes.
This wonderful acronym is a term used for melanocytic tumours which defy accurate classification by pathologists. There is a massive body of literature to reflect intra- and inter- observer variability even amongst experts for some cases. Unfortunately, many of these lesions are very thick so the differential diagnosis is between a lethal melanoma or a completely benign naevus. Fortunately these cases are rare.
In the last decade there has been a significant focus on the molecular genetics of melanoma and its application to the diagnosis of difficult melanocytic tumours. Fluorescent in situ hybridisation (FISH) and Comparative Genomic Hybridisation (CGH) can be extremely useful in difficult cases. A normal FISH result shows 2 copies of each coloured probe (representing a normal diploid population of each region of the genome, figure 32). An abnormal FISH result shows variation from this normal diploid complement (figure 33). In New Zealand, FISH is currently available through IGENZ laboratory in Auckland.

Melanoma pathology: Normal FISH

Melanoma pathology: Abnormal FISH

IGENZ logo